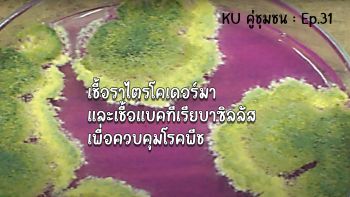

KU คู่ชุมชน
-
![]()
Ep.44 ขนมมัน 5 นาที อร่อยดี ถูกใจ
-
![]()
Ep.43 น้ำเต้าหู้&เต้าหู้แผ่น ลงทุนน้อยกำไรงาม
-
![]()
Ep.42 แซ่บสุดจี๊ด! น้ำพริกจิ้งหรีดโปรตีนสูง ตอนที่ 2
-
![]()
Ep.41 แซ่บสุดจี๊ด! น้ำพริกจิ้งหรีดโปรตีนสูง ตอนที่ 1
-
![]()
Ep.40 เบอร์เกอร์โฮมเมดตอนที่ 2
-
![]()
Ep.39 เบอร์เกอร์โฮมเมดตอนที่ 1
-
![]()
Ep.38 จุลินทรีย์สังเคราะห์แสง เพื่อนที่แสนดีของต้นไม้ ตอนที่ 2
-
![]()
Ep.37 จุลินทรีย์สังเคราะห์แสง เพื่อนที่แสนดีของต้นไม้ ตอนที่ 1
-
![]()
Ep.36 ไอเดียเก๋ไก๋ พวงมาลัยผ้าขาวม้า ตอนที่ 2
-
![]()
Ep.35 ไอเดียเก๋ไก๋ พวงมาลัยผ้าขาวม้า ตอนที่ 1
-
![]()
Ep.34 บ๊ะจ่างเครื่องแน่น อร่อยเต็มคำ
-
![]()
Ep.33 วุ้นมะพร้าวนมสด ตอนที่ 2
-
![]()
Ep.32 วุ้นมะพร้าวนมสด ตอนที่ 1
-
![]()
Ep.31 เชื้อราไตรโคเดอร์มา และเชื้อแบคทีเรียบาซิลลัส เพื่อควบคุมโรคพีช
-
![]()
Ep.30 ทาบกิ่งมะกรูดและการสร้างโรงเรือนเพาะชำสเปรย์หมอกด้วยงบ 2 พันบาท
-
![]()
Ep.29 การปลูกข้าว ตำบลห้วยม่วง
-
![]()
Ep.28 เคล็ดลับการเพาะกล้าผักสวนครัว
-
![]()
Ep.27 เลี้ยงจิ้งหรีดขาย รายได้ดี
-
![]()
Ep.26 การผลิตอาหารสัตว์ ตอนที่ 2
-
![]()
Ep.25 การผลิตอาหารสัตว์ ตอนที่ 1
-
![]()
Ep.24 การเพาะเห็ดเศรษฐกิจ
-
![]()
Ep.23 MaxBeef
-
![]()
Ep.22 เครื่องฝังกลบปุ๋ย
-
![]()
Ep.21 เครื่องรีดนม ตอนที่ 3
-
![]()
Ep.20 เครื่องรีดนม ตอนที่ 2
-
![]()
Ep.19 เครื่องรีดนม ตอนที่ 1
-
![]()
Ep.18 เม็ดไม้ ขำๆ ธรรมชาติ
-
![]()
Ep.17 การปลูกอ้อย ชุมชนตำบลห้วยม่วง
-
![]()
Ep.16 วิธีการเลี้ยงกุ้ง ชุมชนตำบลห้วยม่วง
-
![]()
Ep.15 การทำการเกษตรแบบผสมผสาน
-
![]()
Ep.14 การปลูกผักอินทรีย์ บ้านดอนศาลเจ้า จ สุพรรณบุรี
-
![]()
Ep.13 การแปรรูปผลผลิตทางการเกษตร น้ำพริกดอนศาลเจ้า
-
![]()
Ep.12 การปลูกอ้อย บ้านดอนศาลเจ้า
-
![]()
Ep.11 วิถีชุมชนบ้านดอนศาลเจ้า
-
![]()
Ep.10 โคเนื้อ ดอนตาเพชร กาญจนบุรี กับการบริหารจัดการ
-
![]()
EP.9 "การปลูกเมล่อนระบบเปิด"
-
![]()
EP.8 "กระชาย" โสมไทยที่มากกว่าต้านโรคต่างๆ
-
![]()
EP.7 การแปรรูปมัลเบอร์รี่
-
![]()
EP.6 ปักชำกล้าไม้ สร้างรายได้ให้ครอบครัว
-
![]()
EP.5 ไส้เดือน ทรัพย์ในดิน นราภิรมย์ฟาร์ม
-
![]()
Ep.4 ตอนกิ่งยุคใหม่ ไม่ขูดเนื้อเยื่อ
-
![]()
Ep.3 ธุรกิจมาแรง กับแปลงกล้าสลัด
-
![]()
Ep.2 เมล่อนออร์แกนิค 7 ปี กับความรักและเข้าใจ
-
![]()
Ep.1 กะหรี่ปั๊บไส้เห็ด กรอบ อร่อย ไม่อมน้ำมัน
-
![]()
EP.0 น้ำเห็ด 3 สหาย
เกษตรนำกระแส
-
![]()
EP.08 สอนทำเชื้อไตรโคเดอร์มา ป้องกันและรักษาโรครากเน่า โคนเน่า I เกษตรนำกระแส
-
![]()
EP.07 ใช้ไฟฟ้าโดยไม่ต้องจ่ายค่าไฟฟ้า พลังงานสะอาด 100% I เกษตรนำกระแส
-
![]()
EP.06 อยู่ที่ไหนก็รดน้ำใส่ปุ๋ยได้ ด้วยระบบควบคุมอุณหภูมิภายในโรงเรือน IOT I เกษตรนำกระแส
-
![]()
EP.05 การพาสเจอร์ไรส์น้ำอ้อย ด้วยขวดพลาสติก PET I เกษตรนำกระแส
-
![]()
EP.04 สวนทุเรียนแห่งแรกของทองผาภูมิ I เกษตรนำกระแส
-
![]()
EP.03 การย้ายกิ่งพันธุ์ ด้วยเทคนิคการล้างราก I เกษตรนำกระแส
-
![]()
EP.02 ปักชำมะนาว ทำอย่างไรให้รอด l เกษตรนำกระแส
-
![]()
EP.01 การทำสาวมะนาว ตัดกิ่งมะนาว I เกษตรนำกระแส
KU รู้-ทำกิน
-
![]()
EP.14 ข้าวเหนียวทุเรียนน้ำกะทิ
-
![]()
EP.13 แคคตัส ไม้ทำเงิน
-
![]()
EP.12 หมูแดง&น้ำราด สูตรโบราณ
-
![]()
EP.11 การจับจีบผ้า ทักษะง่ายๆที่คุณก็ทำได้
-
![]()
EP.10 "ขนมสอดไส้" ขนมไทยคลาสสิก
-
![]()
EP.9 "ข้าวหมาก" ขนมไทยคลายร้อน
-
![]()
EP.8 "มะม่วง" เลือกอย่างไรให้โดนใจ
-
![]()
EP.7 เครปกรอบมินิ
-
![]()
EP.6 พวงกุญแจตุ๊กตา
-
![]()
EP.05 หมูกรอบจากหม้อทอดไร้น้ำมัน
-
![]()
EP.4 สวนสวยในบ้าน
-
![]()
EP.3 ขนมไทยหยกมณี
-
![]()
EP.2 มัดย้อมมัดใจ
-
![]()
Ep.01 ขนมเทียนแก้วฉลองตรุษจีน
15 อาชีพแก้จน
-
![]()
15 อาชีพแก้จน EP.15 : ยาหมอบอก สูตรเด็ดทำลูกประคบสมุนไพร
-
![]()
15 อาชีพแก้จน EP.14 : การจัดช่อดอกไม้จากวัสดุธรรมชาติ
-
![]()
15 อาชีพแก้จน EP.13 : ดอกไม้ประดิษฐ์จากวัสดุธรรมชาติ
-
![]()
15 อาชีพแก้จน EP.12 : ขนมมัน 5 นาที อร่อยดี ถูกใจ
-
![]()
15 อาชีพแก้จน EP.11 : ฮอร์โมนไข่ & ฮอร์โมนนมสด เร่งดอก-ผล
-
![]()
15 อาชีพแก้จน EP.10 : เก็บเมล็ดพันธุ์ผักไว้ใช้เองอย่างไร
-
![]()
15 อาชีพแก้จน EP.9 : น้ำเต้าหู้&เต้าหู้แผ่น ลงทุนน้อยกำไรงาม
-
![]()
15 อาชีพแก้จน EP.8 : แซ่บสุดจี๊ด! น้ำพริกจิ้งหรีดโปรตีนสูง
-
![]()
15 อาชีพแก้จน EP.7: จุลินทรีย์สังเคราะห์แสง เพื่อนที่แสนดีของต้นไม้
-
![]()
15 อาชีพแก้จน EP.6 : เบอร์เกอร์โฮมเมด
-
![]()
15 อาชีพแก้จน EP.5 : ไอเดียเก๋ไก๋ พวงมาลัยผ้าขาวม้า
-
![]()
15 อาชีพแก้จน EP.4 : วุ้นมะพร้าวนมสด อร่อยสดชื่น
-
![]()
15 อาชีพแก้จน EP.3 : บ๊ะจ่างเครื่องแน่น อร่อยเต็มคำ
-
![]()
15 อาชีพแก้จน EP.2 : เคล็ดลับการเพาะกล้าผักสวนครัว
-
![]()
15 อาชีพแก้จน EP.1 : เลี้ยงจิ้งหรีดขาย รายได้ดี
KU-รู้-ทำกิน สัญจรงานเกษตร 2020
-
![]()
ของว่างเพื่อสุขภาพ "กล้วยฉาบธัญพืช"
-
![]()
"ไรซ์เบอรรี่หน้านวล" ขนมไทยใครก็ทำได้
-
![]()
"คุกกี้ไส้สับปะรด" ทำกินได้ ทำขายก็ปัง!
-
![]()
"อโกลนีมา" ไม้ประดับฟอกอากาศ
-
![]()
เคล็ดลับปลูก "แคคตัส" ฉบับมือใหม่
-
![]()
เพิ่มมูลค่าสมุนไพร "กระชายดองสามรส"
-
![]()
"ขนมปุยฝ้ายดอกไม้นมสด"
-
![]()
อร่อยสายคลีน "มัฟฟินกล้วยหอมข้าวโอ๊ต"
-
![]()
"ชาใบหม่อน & น้ำตะไคร้ใบเตย" เพื่อสุขภาพ
-
![]()
"แหนมหมู" อร่อยคู่ครัว
-
![]()
"โรลข้าวคลุกกะปิ" ซูชิสไตล์ไทย
-
![]()
"เค้กนึ่ง" อร่อยได้ไม่ง้อเตาอบ
rerun : ถ่ายทอดสดการสาธิตวิชาชีพ งานเกษตรกำแพงแสน 2019
Cooking Show by ครูเป๊าะ
-
![]()
EP.1 : ปุยฝ้ายไหว้เจ้า
-
![]()
EP.2 : คุกกี้หัวใจสื่อรักวาเลนไทน์
-
![]()
EP.3 : ซูชิข้าวไรซ์เบอร์รี่
-
![]()
EP.4 : ช่อผกากรอง
-
![]()
EP.5 : ไส้ถั่วกวนสูตรไม่ใส่กะทิ
-
![]()
EP.6 : ขนมลืมกลืน
-
![]()
EP.7 : ปุยฝ้ายฟักทอง ฉลองตรุษจีน
-
![]()
EP.8 : หมั่นโถวกุหลาบ
-
![]()
EP.9 : แซนด์วิชรักษ์โลก
-
![]()
EP.10 : ตะโก้มันม่วงกะทิสด
-
![]()
EP.11 :บลูเบอร์รี่ชีสพาย ไม่ง้อเตาอบ
-
![]()
EP.12 :ชูครีมหรือเอแคลร์